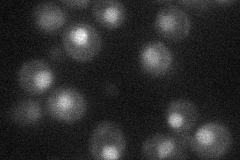
YDR369C
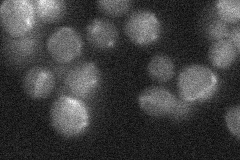
YDR369C
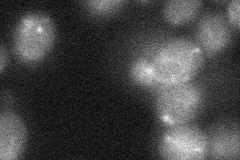
YDR369C
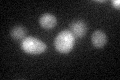
YDR369C
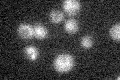
YDR369C

View description
Protein required for DNA repair; component of the Mre11 complex, which is involved in double strand breaks, meiotic recombination, telomere maintenance, and checkpoint signaling
Localization:
Intensity:
Fold change:
Significance:
-
C’ GFP library in SD

below threshold16.28 -
N' NOP1pr-GFP in SD
nucleus21.5373 -
N' TEF2pr-mCherry in SD

nucleus8.13514 -
N' NATIVEpr-GFP in SD
below threshold18.2485 -
N' TEF2pr-VC and Cyto-VN in SD
below threshold23.9932 -
C’ GFP library in SD+DTT
cytosol17.241.05No -
C’ GFP library in SD+H2O2

cytosol16.751.02No -
C’ GFP library in Starvation Media
cytosol15.360.94No -
C’ GFP library on the background of Pup2-DaMP

below threshold -
C’ GFP library on the background of CCT mutant

below threshold16.54531.01582No
